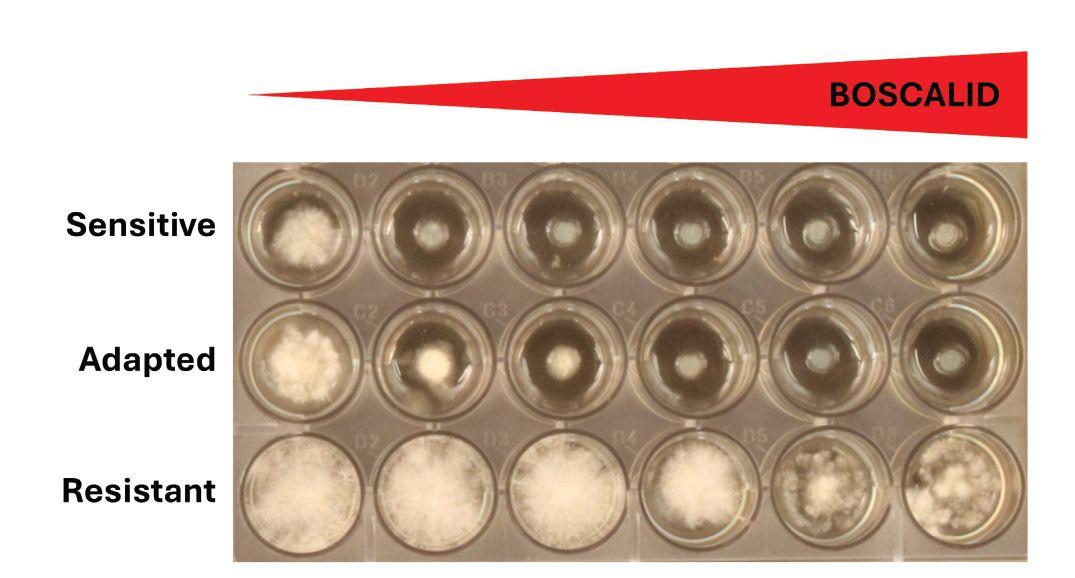

Mitigating
Laying


![]()






Mitigating
Laying


by Kaitlin Berger
As 2025 draws to a close, I’m finding it hard to believe that it was already over six months ago I was sitting at the Canadian Crops Convention the day after the effective date for 25 per cent U.S. tariffs on products of Canada. It felt like we were receiving updates in real time as speakers and panelists shared their perspectives on what Canada’s response should be and what the future held for Canadian agriculture and agri-food exports.
China’s Ministry of Commerce (MOFCOM) also announced a 100 per cent tariff rate on Canadian canola oil and canola meal in March, as part of its anti-discrimination investigation against Canada. Fast forward to August 2025 when MOFCOM announced a 75.8 per cent duty on all Canadian canola seed shipments, as part of its anti-dumping investigation.
This culminated in a memorable statement from Chris Davison, president and CEO of the Canola Council of Canada in a press release: “With this preliminary determination of dumping for canola seed together with the existing 100 per cent anti-discrimination tariffs on canola meal and oil, the Chinese market is effectively closed to the Canadian canola industry.”
Throughout the year, I’ve been privy to many more discussions on the topic of agriculture trade, including Top Crop Manager’s ‘Growing Global: Clarity for Canadian Crop Exports’ webinar in June. While trade talks have been prominent and many have been asking what we’re going to do to develop as a trading partner, it’s been easy to miss the extensive list of advancements being made month after month in the agriculture industry.
I’m reminded of this as I skim through our magazine issues from 2025. In January, you may remember reading about research advancing fenugreek production in Saskatchewan. In February, there was a discussion about the opportunities for crop diversification. More recently, the September issue highlighted the importance of reducing costs by increasing nitrogen use efficiency.
This doesn’t begin to cover best management practices that continue to be improved based on research trials and on-farm experience.
Every year has its ups and downs. Every growing season has its challenges. As we close the curtain on 2025 and you reflect on your year, don’t hesitate to reach out to me to share your perspective on the agriculture stories you’ve heard or read – and the stories you think still need to be told. Email me at kberger@annexbusinessmedia.com or call me at 403-470-4432.

Email: apotal@annexbusinessmedia.com Mail: 111 Gordon Baker Rd., Suite 400, Toronto, ON M2H 3R1
Editor KAITLIN BERGER (403) 470-4432 kberger@annexbusinessmedia.com
Western Field Editor BRUCE BARKER (403) 949-0070 bruce@haywirecreative.ca
National Account Manager QUINTON MOOREHEAD (204) 720-1639 qmoorehead@annexbusinessmedia.com
National Account Manager REENA UPPAL (437) 922-7359 ruppal@annexbusinessmedia.com
Account Coordinator JULIE MONTGOMERY (416) 510-5163 jmontgomery@annexbusinessmedia.com
Group Publisher MICHELLE BERTHOLET (204) 596-8710 mbertholet@annexbusinessmedia.com
Audience Development Coordinator LAYLA SAMEL (416) 510-5187 lsamel@annexbusinessmedia.com
Team Lead/Media Designer BROOKE SHAW
CEO SCOTT JAMIESON sjamieson@annexbusinessmedia.com
Printed in Canada ISSN 1717-452X



BY KAITLIN BERGER
WBASF
ith the goal of helping growers know all their options for next year, Top Crop Manager has put together a list of new canola varieties available for 2026. All information comes from the respective seed companies.
InVigor L355PC offers the strongest disease package to date, including blackleg resistance, strong Verticillium stripe ratings and lodging resistance. Included in the 2024 BASF Agronomic Excellence field trials, InVigor L355PC was one of the top-yielding hybrids across 28 sites. It also features high yield potential, first-generation clubroot resistance, and Pod Shatter Reduction technology – checking more boxes for growers.
BRETTYOUNG
BY 7202LL is a new earlier mid-maturity LibertyLink hybrid. BY 7202LL comes equipped with DefendR-rated shatter resistance and next-generation clubroot resistance, while offering good standability. BY 7206LL is engineered for pod shatter control, advanced clubroot defense, and unbeatable blackleg resistance. BY 7206LL comes equipped with DefendR-rated pod shatter resistance and double layered disease DefendR resistance for blackleg and clubroot, while offering good standabili-
ty and yield potential.
BY 6223TF is BrettYoung’s new Truflex canola hybrid featuring pod shatter tolerance and stacked clubroot resistance that delivers stronger yields and superior harvest security in an early to mid-maturity package.
MC 5230TF is a Roundup Ready mid-maturity hybrid that offers top-end yield potential as well as key agronomy traits to drive yield, with blackleg resistance and Source A resistance to clubroot. MC 5230TF has a 7.6 pod-shatter rating (Canola Council of Canada scale) that allows for later-season straight-cut harvest.
MC 5126LL is a LibertyLink mid-maturity hybrid that offers both excellent yield potential as well as key agronomy traits to support overall yield gain, with strong blackleg resistance and an excellent clubroot rating. MC 5126LL has a 6.0 pod-shatter rating (Canola Council of Canada scale) that allows for early-season straight-cut harvest opportunity.
CP25T2C is a TruFlex hybrid with exceptional yield potential and early to mid-maturity. It has both classic and newer clubroot protection with resistance to the clubroot pathotypes 3A, 3D, 3H, 8A, 8E, 8N, 9E, 5L, 8P,
8D, 5G, 5C, 5X and 5I. It scores 7.3 on the Canola Council of Canada pod shatter score and has an R rating for blackleg with resistance in groups E and G with Rlm4 and RlmS major gene resistance.
CP25L3C is a LibertyLink tolerant hybrid with a strong pod shatter score of 7.2, strong yield potential and excellent early season vigour. It is a mid-maturity hybrid with an R rating for blackleg and excellent clubroot resistance to pathotypes 3A, 3D, 3H and 9E.*
Both WinField United Canada varieties are available at independent ag retailers.
*Additional characterization is pending. Ask your local CROPLAN representative for more information.
PV 662 LCM is a brand-new mid-season hybrid built for Western Canadian conditions. With multigenic clubroot resistance, harvest management flexibility and strong yield potential, this LibertyLink hybrid is designed to perform under pressure and protect your yield.
PV 663 LCN is a next-generation hybrid combining early maturity, clubroot protection and the harvest security of NTACT Technology. With dependable pod integrity and flexibility to straight cut or delay swath, this variety reduces harvest losses and extends pod fill for higher returns. It’s a solid fit across all canola acres looking for yield, reliability and peace of mind.
PV 664 LCN sets a new standard for full-season canola. It combines top-end yield potential with clubroot resistance and the enhanced harvest control of NTACT Technology. This hybrid isn’t just straight cut ready, it’s built to hold up under pressure, protect every pod and deliver longer pod fill for maximum yield.
PV 784 TCN is the newest canola hybrid featuring NTACT Technology for dependable pod integrity and straight-cut confidence. This mid-season hybrid brings solid yield potential, strong agronomics and clubroot resistance to keep crops protected and performing.
DEKALB DK904TF is the highest yield-potential hybrid in the 900 series, with yield potential of 112 per cent of Pioneer P515G. As a TruFlex canola, it provides enhanced weed control and flexibility in spray timing and rates (compared to Roundup Ready canola). DK904TF delivers DEKALB’s highest-performing genetics, with the Straight Cut Plus trait for enhanced pod shatter protection (7.2 on the Canola Council of Canada canola shatter scale), and a total disease package, including Clubroot Resistance Plus and blackleg resistance
(Rlm7, RlmS). This hybrid is a must-have in high-risk clubroot zones, protecting growers from the most frequently found pathotypes in Western Canada. And growers can go into harvest with confidence—as a true DEKALB canola hybrid, expect to be in sooner and out quicker with an earlier, faster, smoother harvest.
Pioneer 100 Series P1540L is the highest-yielding Pioneer brand canola ever, with our new Pod Shatter Premium (PSP) technology allowing it to be straight cut with confidence. P1540L features a broad and robust clubroot pathotype resistant package (CR8 (5)), seedling and adult plant resistance to blackleg, Verticillium stripe tolerance, and has very good standability and lodging resistance.
Pioneer 100 Series P1530G is setting a new yield performance standard for Optimum GLY canola. P1530G features a strong clubroot pathotype resistance package (CR6 (4,5)), good Verticillium stripe tolerance, moderately resistant (MR) for blackleg – adult plant resistance and excellent early growth performance.
Pioneer brand P524G is a new, early maturing Optimum GLY canola hybrid that features a robust clubroot pathotype resistant package (CR6 (4,5)), very good early growth, strong blackleg adult plant and seedling resistance, and good Verticillium stripe tolerance.
Brevant seeds B4021 is a new, high-performing Optimum GLY canola hybrid, featuring Pod Shatter Premium (PSP) Technology allowing you to straight cut with confidence. Achieve an optimal harvest window with this mid-maturity canola hybrid allowing for timely and efficient crop management. Protect your crop from clubroot and other diseases with comprehensive resistance to multiple clubroot pathotypes (CR6) and strong seedling and adult resistance to blackleg.
Brevant seeds B3901N is a new, high-performing LibertyLink Nexera canola hybrid with an exceptional disease package and improved pod shatter tolerance. B3901N is suitable for all growing regions, with very good early growth and emergence to ensure a strong start. B3901N offers clubroot (CR7) resistance, Verticillium stripe tolerance and strong adult blackleg resistance, effectively mitigating the impact of these key diseases.
Brevant seeds B4970N is the first Brevant seeds Nexera canola hybrid with the Optimum GLY trait, offering enhanced pod shatter tolerance, increased yield potential and robust disease protection. With a comprehensive disease resistance package, including both seedling and adult blackleg resistance, as well as a (CR12) clubroot package that is resistant to multiple pathotypes, Brevant seeds B4970N is an excellent addition to your crop rotation strategy, effectively managing Group 1 resistant wild oats, volunteer LibertyLink canola and other common weeds.
CS4100 LL is a mid-maturity LibertyLink canola hybrid with PodProtect, rated 7+ for pod shatter for excellent straight-cut flexibility. It offers a strong disease package with R-level blackleg (R-E2G) and first- and second-generation clubroot resistance, yielding 105 per cent versus DEKALB DK400TL in 2024 Breeder Trials (n=11). Learn more at canterra.com and watch for upcoming LibertyLink hybrids for 2026.
BY KAITLIN BERGER
Top Crop Manager’s annual photo contest showcased plenty of images depicting Canadian agriculture, including brilliant sunsets in the field, inevitable long days during harvest and the loveable dog waiting in the farmyard. The winning cover photo from Kaitlin Kolotylo captured a young girl with her puppy waving to Dad as he combines the field. It’s a mixture of some of the best things about agriculture – the grit and hard work that happens in the field, the excitement of harvest and sharing it all with the next generation of farmers.






Best practices for mitigating risk to crops and beneficial insects.
BY MATT MCINTOSH
Aphids are the top insect pest for soybeans. With the proliferation of insecticide-resistance among some aphid populations in states like Iowa and Minnesota, Manitoba soybean growers must be increasingly flexible in how they manage the pest.
Soybean aphids originate from Asia and were first found in the United States in 2000. The first confirmation of them in Manitoba came the following year. While the pest can’t overwinter in Manitoba, it can travel enormous distances on the wind, and it proliferates quickly in warm, dry conditions.
Some years it can be a significant and widespread problem – as seen in 2017 – and in other years, it’s comparatively non-existent. This erratic population growth may be inconsistent, but it means Manitoba soybean growers do not have to spray for aphids every year.
John Gavloski, entomologist at Manitoba Agriculture in Carman, Man., says growers should use economic thresholds to determine if insecticides are necessary. “The threshold is 250 aphids per plant on average, and an increasing population, which usually means at least a second trip to the field to scout. Soybeans can compensate well for lower levels of aphids. Economic thresholds give the natural enemies of aphids a chance to do the job for you,” says Gavloski. Natural enemies include lady beetles, green lacewings and hover flies.
“The economic injury level, the smallest number of

insects (or level of injury) that cause damage equal to the pest management costs, is 670 aphids per plant, but we definitely don’t want people to get there before they spray because aphid populations increase so quickly.”
ABOVE Aphids can proliferate quickly in warm, dry conditions and cause injury to soybean plants.
Historically, soybean growers have often reached for pyrethroids when aphid control was required. Overuse of this class of insecticides in the United States – as well as unnecessary applications and not applying at the recommended rate – contributed to the emergence and proliferation of pyrethroid-resistant populations.
Gavloski says Manitoba growers inherit this problem from south of the border when soybean aphids blow in from the U.S. That’s why he recommends they be extra vigilant when conditions are favourable. The good news is the problem in Manitoba has not become chronic, as has happened in some areas in the U.S. However, research projections indicate that – while soybean aphids currently are not known to overwinter in Manitoba, that could change in the future.
“We rarely find soy aphids in Manitoba at all until at least July. It’s usually anywhere from the first week to
almost the end of July, although there have been some years when it was not reported until August. They don’t seem to be here at detectable levels early in the season,” says Gavloski. The northern limits of where conditions normally favour overwintering, however, is “not that far south.”
While Canadian farmers are not spraying for aphids every year, things are different in parts of Minnesota, Iowa, as well as North and South Dakota. Janet Knodel, professor and extension entomologist at North Dakota State University (NDSU), says 2017 was the first year of significant complaints about a lack of pyrethroid performance in soybean aphid control. Dry conditions in 2024 also brought significant problems, while comparatively cool and wet conditions have provided respite in 2025, at least as of July 31.
“Most soybean growers follow the economic threshold to decide when to treat for soybean insect pests,” says Knodel. “However, because pyrethroid insecticides like bifenthrin and lambda-cyhalothrin are relatively inexpensive, they are often overused—not just for soybean aphids, but also for other pests like grasshoppers or bean leaf beetles.” This overuse is

CONTINUED ON PAGE 17 ABOVE

• Proprietary bioengineered carrier.
• Exceptional flowability and low dust.
• Maximizes phosphorus uptake.



Bayer Crop Science Canada has launched Vyconic soybeans, a new trait technology that will be the first to feature tolerance to five herbicide active ingredients. As a major milestone in weed control, this will give growers more flexibility, multiple effective options for managing weeds, and it will decrease the risk for herbicide resistance.
With mesotrione and 2,4-D, Bayer is adding two new herbicide active ingredient tolerances to XtendFlex soybeans for a total of five active ingredients: dicamba, glufosinate, mesotrione, 2,4-D and glyphosate. These are an effective combination against a wide range of broadleaf weeds, including kochia, fleabane, Palmer amaranth and waterhemp.
“At Bayer, we recognize how resilient and determined Canadian farmers are as they adapt to and overcome the challenges of weed pressure” says David Kikkert, Canada corn and soybean portfolio lead. “Our new Vyconic soybean trait package offers solutions for weed control and application flexibility, equipping farmers to create custom weed management plans that fit their specific needs. By investing in advanced genetics and innovative solutions, we support farmers in achieving higher, more consistent yields with increased effectiveness and better outcomes.”
According to a Bayer Crop Science Canada media release, the U.S. and Canadian market introduction for Vyconic soybeans is anticipated for the 2027 planting season.
SASKATOON FACILITY EXPANSION WILL INCREASE CAPACITY OF SULPHUR FOCUSED FERTILIZERS

Shell Trading Canada is investing in boosting production capacity for enhanced nitrogen sulphur fertilizers at Northern Nutrients’ current facility in Saskatoon, Sask. Following a new ownership structure, this project will triple the current annual capacity from 50,000 mt to 150,000 mt.
Northern Nutrient uses Shell Thiogro Technology to produce enhanced nitrogen sulphur fertilizers, including their product Arctic S 11-0-0-75S. An Arctic S presentation says this product has a urea base with micronized particle size, allowing for quick breakdown and crop availability. According to a Northern Nutrients media release, it’s
composed of 11 per cent nitrogen and 75 per cent micronized elemental sulphur.
“Since local production of Arctic S began in 2022, the market response across North America has exceeded our expectations making now the perfect time to expand our production capacity, and Shell the perfect partner to do it with,” says Ross Guenther, CEO and co-owner of Northern Nutrients.
The Arctic S presentation also notes the product was imported into North America from 2018 to 2021 before the Saskatoon facility was built in 2022. The product was used on approximately 2 million acres in Western Canada and the U.S. in 2023. This collaboration between Northern Nutrients and Shell Trading Canada indicates a shared dedication to providing growers with efficient fertilizer solutions.

Unverferth Mfg. Co., Inc., manufacturer of grain-handling equipment and more, reported the introduction of the new Brent Avalanche 3298 grain cart in a news release following Ag in Motion in Saskatchewan in July. The new model is the industry’s largest capacity grain cart with 3,150-bushel capacity. It can fill three semi loads of grain and can unload at a speed of up to 1,000 bushels per minute.
The model has dual-augurs, powered by an exclusive drivetrain with a belt-driven 20-inch-diameter horizontal auger working in conjunction with a direct-drive 90-degree gearbox for the 24-inch vertical auger. It also has an Equalizer SP track system featuring a 50-inch-wide belt and 128-inch footprint.
“The low-profile, dual-auger design offers easy filling and the steepsloped hopper handles high-moisture grain with ease for complete cleanout,” says the news release.
Other features include large observation windows, a side-mounted ladder with ergonomic design and single-point lubrication of auger components – all for simplified use.
The New Product Roundup is a concise update of some of the latest products and advancements in the industry.




Exploring supplemental pollination as a means to rescue canola yields from heat and drought stress impacts.
BY CAROLYN KING
Managed bees, including honey bees and leafcutter bees, provide vital pollination services in hybrid seed production for canola. University of Lethbridge researchers are now exploring supplemental pollination to see if it might also offer an innovative way to help minimize yield losses in canola crops exposed to hot, dry conditions.
This project is backed by the need to adapt to the predicted increasing risk of weather challenges such as heat waves and droughts, which are major threats to Prairie canola production. “It is important to be prepared with strategies aimed to proactively mitigate the effects of climate change on crop yields as well as bee health, and in turn improve sustainability and food security,” says Fairo Dzekashu Foryuy, postdoctoral researcher at the University of Lethbridge, involved in the research group led by Shelley Hoover, the principal investigator and an associate professor.
TOP Foryuy works with canola plants under special grow lights in one of four greenhouse chambers; the chambers allowed comparison of different pollinator exposures, temperature cycles and watering conditions.
The project is funded by the Alberta Canola Producers Commission and Results Driven Agriculture Research (RDAR) under the Canola Agronomic Research Program (CARP).
Pollinators and canola crops have a great partnership that benefits both partners. For pollinators such as bees, canola fields offer plentiful supplies of nectar and pollen for efficient foraging. Nectar provides carbohydrates for the bee colony, and pollen provides protein and other nutrients for brood rearing.
“Bees and other pollinators transfer pollen between canola flowers, allowing for the formation of pods and seeds. This is especially important in the hybrid canola seed production industry in southern Alberta, which uses different parent lines to create the commercial hybrids grown across Canada,” explains Autumn Barnes, research manager for Alberta Canola. “There
are over 20 million acres of canola grown each year in the Canadian Prairies, and canola flowers are a significant source of nutrition for bees.”
In addition to the key role in hybrid seed production, some studies show pollinators can also help boost yield, quality and timeliness of commodity canola crops. For instance, insect pollination can help increase the number of pods per plant, the number of seeds per pod, as well as seed weight. It can promote earlier and more uniform flowering, shorter bloom time, earlier pod-setting, earlier maturity and fewer green seeds.
Heat and drought stress, especially during canola’s reproductive stages, can have serious yield impacts.
“Canola is a cool season crop. Hot temperatures (above 30 C) can cause pod abortion, reduced pod number, reduced seed number and reduced seed size. Since farmers get paid by the bushel of seeds produced, heat stress can be very impactful for profitability,” says Barnes.
“Drought can be particularly hard on canola plants. Dry conditions in the early season may result in lower emergence and less vigorous vegetative growth, and as the season progresses, dry conditions can result in fewer flowers, fewer pods, smaller seeds and fewer seeds in each pod.”
Hot and dry conditions are detrimental for pollinators as well. “Heat waves and water stress are known to have direct impacts on pollinator or bee thermoregulation and ultimately affect their foraging patterns. Typically, these stresses are known to also suppress bee flight activities,” explains Foryuy.
In the case of honey bees, they forage for water as well as for nectar and pollen because they need water to drink, feed their larvae and cool the hive in hot weather.
Furthermore, the heat and moisture stress impacts on canola, such as reductions in flower size and number, and problems in pollen development, also reduce the rewards offered by the crop to pollinators. “In a nutshell, heat waves and droughts are known to greatly reduce the plant’s nectar volume, increase its nectar concentration, and significantly reduce pollen production,” he says.
“There is some evidence to suggest that the presence of pollinators can affect canola’s ability to withstand heat and drought conditions. This project helps to better understand the interactions between pollinators and heat and drought stress in canola,” says Barnes.

This proof-of-concept project provides an initial look at whether this tool might work.
ABOVE Co-op student Daniela Iniguez-Specia records the number of daily new flowers produced and pollinator visitations on each plant.
Foryuy outlines the project’s two objectives. “The first objective was to examine how heat and water stress affect canola’s flowering phenology and flowering traits such as flower number, flower size, nectar volume, nectar concentration, pollinator visitation and seed yield.”
“Secondly, we aimed to investigate if the introduction of pollinators during flowering would advance phenological transitions – that means shortening the flowering cycle or advancing the flowering cycle – and if it would improve canola yield and produce a yield compensatory response under adverse temperature and moisture conditions.”
The project was conducted at the University of Lethbridge in four greenhouse chambers so the project team could control the temperature and moisture conditions and the exposure of the canola plants to pollinators. The work started in 2022, with most of the intensive greenhouse activities taking place from November 2023 to March 2024.
The team compared three canola varieties: a historical, open-pollinated variety called Westar; an early-maturing modern hybrid; and a late-maturing modern hybrid. According to Foryuy, these two modern hybrids are commonly available and frequently grown by Prairie farmers.
The pollinator insect in this project was the bumble

bee species Bombus impatiens, which is often used as a pollinator in commercial greenhouses. “Many researchers have tried to use honey bees in greenhouses but never successfully because honey bees get confused by all the reflection off the lights within the greenhouse. So, we used bumble bees in this project,” explains Foryuy.
The project’s main treatments compared differences in exposure to the pollinators: plants with no pollinator exposure; plants with pollinator exposure for the entire duration of bloom; and plants with pollinator exposure beginning seven days after the start of the heat and drought treatments.
Two of the greenhouse chambers were at elevated temperatures, and one of these high-temperature chambers had bumble bees. The other two chambers were at standard temperatures for the region, and one of these chambers had bumble bees. The temperature setups followed a typical 24-hour cycle for summer conditions in the Lethbridge area. For the elevated temperature treatment, the temperature rose gradually from 13 C at 1 a.m. to a peak of 31 C between 12 noon and 3 p.m., and then gradually descended back to the nighttime low of 13 C. Similarly in the standard temperature treatment, the temperature rose from 11 C at 1 a.m. to a maximum of 26 C between 12 noon and 3
BELOW This chamber had standard temperature conditions and no bees, with half the plants receiving standard watering and half receiving reduced watering.

LEFT The experiment compared the effects of the different growing conditions on three canola varieties: a late maturing hybrid (LM), Westar (WES) and an early maturing hybrid (EM).
p.m. then fell back to 11 C.
Within each greenhouse chamber, the irrigation system was set up so that half the plants received the standard watering treatment, which was 64 per cent of the soil’s water-holding capacity, and the other half received the reduced watering treatment, which was 21 per cent.
“We monitored and recorded the phenological cycle of the plants and measured crop yields such as number of pods, and number of seeds per pod. We weighed the seeds to get the per cent seed weight and 1,000-seed weight. And we evaluated seed quality and the quality of the floral rewards ... including nectar volume, nectar concentration and flower size.” They also monitored pollinator visitations.
At present, Foryuy is completing analysis of the experiment’s results, but he can share some of his initial findings.
“We’re getting some quite interesting results. We’ve seen that heat accelerated flowering onset and peak of bloom. And heat and drought reduced flowering duration. [In contrast,] under standard conditions, the plants bloomed later, they produced more flowers, and they extended their flowering period. These in turn helped increase the accessibility of the flowers and their attractiveness to pollinators. And we also observed that seed and pollen production was higher when plants were grown in the standard conditions,” he notes.
They found pollinator visitation is a key factor in increasing canola yields, particularly under the standard conditions. The early introduction of bees in anticipation of or during adverse growing conditions can advance and shorten the flowering cycle of canola plants and improve the crop’s yield. This finding suggests supplemental pollination might have potential as a tool for rescuing a canola crop from the impacts of high temperature and low moisture conditions.
Foryuy is excited that this project could provide valuable information for Prairie canola growers and beekeepers. “I think the results from this work will inform growers about the effects of realistic levels of heat and drought on canola crops. For example, the three varieties that we used in the project can serve as a baseline for comparison with the canola varieties that growers plant.”
contributing to resistance issues in soybean aphids, says Knodel, noting that cross-resistance between these pyrethroid products has been documented in small-plot research and lab bioassays.
Staying informed on insecticide resistance is a critical first step. NDSU resources recommend scouting fields every seven to ten days, and treatment within five to seven days from the point the economic threshold was reached.
If the application threshold is reached and the problem is still growing, aphid-specific insecticides are now available to overcome pyrethroid resistance, while leaving non-target insects unharmed. Regardless of product, if more than one insecticide application is required, Gavloski says growers should rotate insecticide groups, not just to a different product.
Knodel says the same, pointing to products – Sivanto Prime and Sefina – as examples of alternative chemistries specifically designed for control of aphids and other leaf piercing-sucking insects, such as leafhoppers. Both are registered and marketed for soybean
aphids on soybeans in Canada.
Pyrethroids can still be effective if the soybean aphid population is not resistant. However, its effectiveness degrades once temperatures reach the upper 20s (Celsius). This means soybean growers should apply it later or earlier in the day, when temperatures cool, if not a different day altogether.
Regardless of the product applied, proper nozzles and spray volumes are needed. NDSU extension resources recommend 15 to 20 gal./ac. by ground, or 3 to 5 gal./ac. by air, with 40 lb./in.2 of pressure. Fields should be scouted post-application to confirm application effectiveness.
Crop stage also matters. “If you’re above threshold and anywhere from R1 (beginning bloom) to R5 (beginning seed), those are the critical stages to protect. Once they reach R6, full seed set, you’re less likely to get a return even at higher levels. Basically, by then the yield has been set,” Gavloski says.
Other advice includes giving the natural enemies a chance. “Sometimes they’re noticeable on the plants as well,” says Gavloski. “A lot depends on the south winds. Aphids can get pushed a long way.”


FLEA BEETLE
CUTWORMS
ASTER LEAFHOPPER
BERTHA ARMYWORM
CABBAGE SEEDPOD WEEVIL
CANOLA FLOWER MIDGE
DIAMONDBACK MOTH
GRASSHOPPERS
LYGUS BUGS
WIREWORMS










Grande Prairie, AB
For the first time, Top Crop Summit is expanding beyond Saskatoon with a NEW second event in Alberta’s Peace Region. Designed for growers, agronomists and crop advisors, the summit delivers expert agronomy research, insights, and production strategies tailored to the Peace Region—helping you make informed decisions and boost productivity next season.






A Prairie research project investigates the fungus’ adaptation and resistance to fungicides.
BY CAROLYN KING
Fungicides play a vital part in the control of Sclerotinia sclerotiorum , the fungus that causes Sclerotinia stem rot, or white mould, in canola. However, a Prairie-wide project is finding that some isolates of this fungus have higher insensitivity to fungicides commonly used to control this very damaging disease.
Sclerotinia sclerotiorum is a widespread soil-borne pathogen that plagues hundreds of plant species, including crops like soybean, dry bean, sunflower and potato, as well as canola. Therefore, the use of fungicides for Sclerotinia control is not unusual in Western Canada. However, frequent use of a fungicide increases the risk of Sclerotinia becoming insensitive to that fungicide’s mode of action, just like frequent herbicide use increases the risk of herbicide resistance in weeds.
“Fungicide insensitivity takes two forms: adaptation and resistance,” explains Dwayne Hegedus, a research scientist with Agriculture and Agri-Food Canada (AAFC) in Saskatoon. He is co-leading the project with his AAFC colleague, another research scientist, Lone Buchwaldt.

Sclerotinia stem rot in canola plants.
“Adaptation occurs when a pathogen isolate shows a higher degree of insensitivity to fungicide concentrations compared to the majority of known isolates of the same fungal pathogen,” says Hegedus. “This can be due to small genetic changes in the isolate that, for example, may prevent the fungicide from getting into the fungal cell because of changes in the cell wall, or may increase the isolate’s ability to export the fungicide out of the cell. In other cases, isolates deploy enzymes that modify or degrade the fungicide.”
“These changes in tolerance can impact a fungicide’s field performance. However, a grower might be able to manage this problem by increasing the amount of fungicide within certain limits as indicated by the fungicide label,” he says.
“Fungicide resistance is far more dramatic. It is caused when a mutation occurs in the gene encoding the protein that is targeted by the fungicide. In this case, the fungicide can no longer interact with the target and the fungal isolate is completely resistant to very high levels of the fungicide. Some mutations confer resistance to fungicides with the same mode of action and that is when things become especially problematic.”
With this type of resistance, no matter how much more of the fungicide is applied, the disease still wouldn’t be controlled. A fungicide with a different mode of action would be needed.
Fungicide application is a useful tool even for canola varieties with some Sclerotinia tolerance. “The companies strongly suggest that the tolerant varieties be used in concert with fungicides to provide maximum protection,” says Hegedus. “The two strategies work very well together.”
The idea for this project arose out of Hegedus’s role as a member of the Canola Council of Canada (CCC) Sclerotinia Stem Rot Steering Committee, which discusses issues related to Sclerotinia management in canola. This multistakeholder committee includes representatives of government, academia, breeding and fungicide companies, extension agencies and growers.
The committee knew that fungicide insensitivity in Sclerotinia sclerotiorum had become an issue in many jurisdictions, including Europe, China, Australia and parts of the United States. “We were curious as to what the situation was in Canada, and if there was any publicly available information,” says Hegedus.
He worked with the CCC to conduct a global meta-data analysis (an advanced literature review) on this issue. “We found that information was available from most other parts of the world, even China, which historically has not been very forthcoming with such information. However, there was a severe lack of published information pertaining to the situation in Canada with only a single report on benomyl resistance (now deregistered) from about 15 years ago.”
This lack of publicly available information about fungicide insensitivity to Sclerotinia in canola in Canada also applies to fungal pathogens in most other field crops. “If there is fungicide testing in Canada, it is within the private sector and not publicly available,” he says. “So, farmers are buying fungicide products without knowing whether the active ingredient is fully working.”
Fungicide insensitivity information also benefits other stakeholders, especially fungicide companies who need this information to help with decisions about product registration or deregistration and new product development.
“Fungicide resistance is far more dramatic. It is caused when a mutation occurs in the gene encoding the protein that is targeted by the fungicide.
To fill the information gap on Sclerotinia sensitivity to fungicides used in canola, Hegedus has teamed up with Buchwaldt and Edis Dzananovic, a research associate who is also with AAFC in Saskatoon.
In this project, which started in 2023, the three researchers are testing for fungicide adaptation and resistance in Sclerotinia isolates collected in canola-growing regions across Alberta, Saskatchewan and Manitoba between 2023 and 2025. The project team has been fortunate to get help from provincial crop specialists, CCC agrologists and individual farmers who send samples of sclerotia (resting bodies) and Sclerotinia-infected stem pieces each fall.
In addition, Buchwaldt is providing another set of Prairie isolates, which were collected in 2010. These isolates provide a baseline so the researchers can determine if fungicide insensitivity has increased over the 15-year period. Initially, the isolates were tested for insensitivity to prothioconazole (Group 3), boscalid (Group 7) and azoxystrobin (Group 11). That work was funded under the Sustainable Canadian Agricultural Partnership (Sustainable CAP), with funds from the CCC through the canola grower associations in the three Prairie provinces as well as AAFC. “Those three fungicide groups were present in most of the commercial fungicides that were registered in 2022,” explains Hegedus.
Based on early results, the team has been able to obtain further funding to expand the testing to include three additional fungicides: pydiflumetofen and fluopyram (both Group 7), as well as fludioxonil (Group 12). The new funding is from the Canola Agronomic Research Program (CARP),
which is supported by the three provincial grower associations, and Alberta’s RDAR (Results Driven Agriculture Research) program. “Together these six fungicides comprise almost all of the registered groups and chemistries that are currently available for control of stem rot in canola.”
First, the isolates are sent to a company in Germany for fungicide testing using standard protocols determined by the Fungicide Resistance Action Committee (FRAC). Such testing is mandatory for fungicide companies in Europe. “Any isolate that shows higher levels of adaptation or resistance, we then retest ourselves inhouse using the same protocols and same set of control isolates which the company has provided to us,” explains Hegedus. “And if we find resistance, we sequence the genes that encode the target protein to identify the mutation that is conferring that resistance.”
The DNA markers used in this work could also be used as markers in high-throughput testing,
ABOVE An example of the testing system used to evaluate fungicide sensitivity in isolates of Sclerotinia (the white fungus), in this case showing how each isolate is affected by increasing amounts of boscalid.
such as a laboratory offering a Sclerotinia sensitivity testing service for Canadian farmers.
In 2023 and 2024, the project team tested the 2010 collection (133 isolates) and the present-day isolates collected so far for insensitivity to azoxystrobin (Group 11), prothioconazole (Group 3) and boscalid (Group 7). This initial set of tests has produced some important results. “Azoxystrobin has been in use the longest [of the three fungicides], more than 20 years. However, we have not observed high levels of adaptation, and we didn’t find any resistance,” notes Hegedus.
They also didn’t find resistance for prothioconazole. “But we observed generally higher levels of adaptation, compared to sensitive isolates, across all growing regions,” he says. There is some concern for prothioconazole.
“For boscalid, we did not see high levels of adaptation, but we did identify resistance in one isolate from Manitoba. This isolate was 100,000 times less sensitive to the fungicide [than the sensitive control isolate]. When we did DNA sequencing of the target gene, which is called succinate dehydrogenase, we found a mutation already known to confer resistance not only to boscalid but to almost all the Group 7 fungicides. So that is a concern.”
Hegedus says they hope the boscalid-resistant isolate is a one-off. “The fact that we found it among a relatively small group of isolates from Manitoba is worrisome. Boscalid resistance is common and well documented in Europe and China. Our finding illustrates that the same might happen in Canada.”
The project’s sample collection in 2025 includes a focus on the area in Manitoba where the boscalid-resistant isolate was found in 2024, to learn
more about the situation there. The project’s fungicide sensitivity testing, now expanded to all six fungicides, will provide a complete dataset for the 2010 collection and for isolates from all three provinces collected in the 2023, 2024 and 2025 growing seasons. In addition, Buchwaldt is seeking decades-old Sclerotinia isolates to examine their sensitivity before today’s common use of fungicides.
The Sclerotinia Stem Rot Steering Committee is working with the CCC to keep the Sclerotinia management information on the CCC website up to date to help growers as they make management decisions. Hegedus, who comes from a farming background, also offers some commonsense reminders to reduce the risk of fungicide insensitivity in Sclerotinia-susceptible crops. “Educate yourself so you know the mode of action of fungicides you plan to use. You don’t have to know all about their chemistries, but at least know what groups they fall into.
“Rotate your fungicide groups, just as you should be rotating your herbicide groups. And if the situation and the economics allow, try to use products that have two fungicides from different groups to avoid buildup of resistance.”
“Keep in mind that many of the fungicide products have the same active ingredients but under different commercial names are applied to several different crops,” says Hegedus. “So, crop rotation and fungicide rotation should be considered together.”
He also notes: “Patent protection has expired on some fungicides, so many cheap generics have appeared on the market. The patent has expired on prothioconazole, and this year alone, six or seven new prothioconazole products were registered for control of Sclerotinia in canola. Overuse of these single-active-ingredient products will increase the selective pressure and can accelerate the development of adaptation or resistance in the Sclerotinia population in your crops.”
Unfortunately, at present, you wouldn’t be able to get your Sclerotinia samples tested if you suspected fungicide insensitivity might be developing in one of your fields. According to Hegedus, no company in Canada is providing such a testing service.
The project team hopes to change that. “We have been advocating that Sclerotinia sensitivity testing needs to be available to farmers so they can monitor fungicide efficiency situations and make informed decisions. This could be expanded to many other diseases and field crops,” says Hegedus. “We hope to work with new or existing companies, including seed testing companies, who might see a business opportunity in offering fungicide sensitivity testing.”




Temperature matters when it comes to insect management.
BY JOEY SABLJIC
It doesn’t take long for insects to multiply and thrive within stored grain. Even with a single pair of insects – a male and female – the population can explode to more than one million after four months under the right conditions. One adult female can lay eggs continuously and those larvae become adults in less than one month at optimum conditions and lay their own eggs. The result is overlapping generations of insects multiplying within a storage bin – feeding on grain, causing spoilage and other serious issues.
While it seems plausible the Canadian Prairie winters would solve the insect problem, the cold is not as effective as one might think. Researchers at the University of Manitoba’s Department of Biosystems Engineering – led by Fuji Jian, associate professor at the university – have been looking into what temperatures are needed to keep insect populations under control, how quickly they reproduce and how these insects move and behave within stored grain.
“For such small creatures, these insects are a lot cleverer than you might think,” says Jian. “Some species are excellent at finding the places within grain with the exact right temperatures and moisture content.”
According to Jian, among the 160 or so identified species of storage mites and insects, there are two main pests in Canada – the rusty grain beetle and red flour beetle. For either pest to survive and multiply within a typical grain bin, the temperature must be around 25 to 35 Celsius (C). “In Canada, most of the storage insect issues actually happen after harvest, through the late summer and into November, because that’s when you have the most ideal temperatures for reproduction,” explains Jian.

IS HEAT THE ANSWER TO STORAGE INSECT POPULATIONS?
ABOVE Fuji Jian explores the temperatures needed to keep insect populations under control in grain storage.
Jian and his team have been looking at the impact of temperature on storage insects. They’ve found that when temperatures climb any higher than the ideal 37.5 to 38 C, insects will move around to try to find cooler spots. If temperatures were to hit over 42 C, most insects wouldn’t be able to survive for more than a handful of days. If you crank up the heat to 50 or 60 C, the insects’ survival plummets to minutes or seconds. However, because growers want to avoid excess heating in their grain bins, controlling insects with higher temperatures isn’t really an option.
Another issue is that high insect populations generate their own heat. “When insects multiply within grain storage, they produce heat. And then when they feed on and damage grain, it also produces heat due to respiration.” says Jian. “At the same time, all that respiration and heat raises the grain’s overall moisture level and causes mold spores to multiply. It’s very much a chain reaction.”
This chain reaction can create numerous, large hot spots within stored grain as insects move from one spot to another to escape rising temperatures, leaving plenty of damaged grain in their wake, adds Jian. “What we’re finding is that as the mould from most hot grain multiplies, the hot spots gradually enlarge and that’s really what influences the motion of the insects in storage,” he says. “The idea that they’re just staying in one spot just isn’t the case.”
The rusty grain beetle and red flour beetle are two of the main pests in Canada, among the 160 or so identified species of storage mites and insects.
If high heat isn’t the answer for controlling insects in stored grain, perhaps cold – or extreme cold – could provide a solution. Another branch of Jian’s research has involved looking at the survivability of different insect species under cold temperatures.
The general rule, says Jian, is the insects tend to slow down and stop reproducing once temperatures get below 15 C. However, Jian and his team have found low temperatures can have vastly different impacts on controlling different insect species. For example, temperatures less than 5 C usually prove fatal for red flour beetle, but rusty grain beetle is a different story.
“Rusty grain beetles are challenging because they’re extremely cold hardy,” explains Jian. “They are very well acclimated to colder Canadian temperatures, which makes them the most concerning storage pest for Canadian farmers.” He points out that rusty grain beetles have been found to survive at temperatures as low as -15 C or -20 C.
“The key in dealing with rusty grain beetles is to use aeration to cool down your grain as quickly as possible,” says Jian. “If you’re fast enough, the beetles might only
survive for a couple of weeks. But if that cooling is slow and gradual, then you’re giving them time to acclimate and increasing their chance of survival.”
Grain, he adds, has very low thermal conductivity, meaning that it can be extremely slow to both store heat and release heat. In other words, growers shouldn’t wait for natural, external temperatures to work their magic – especially if beetle populations are already on the rise.
“Grain in the winter will rarely get down below freezing – even if outside temperatures are minus 40,” he says. “If you have a bin that’s 10 meters in diameter and 30 feet tall, the grain temperature in the very centre can still be higher than 25 degrees. Even close to the wall of a bigger bin, you won’t see temperatures go low enough to render the beetles inactive.”
While rapidly cooling grain below 15 C won’t entirely eliminate rusty grain beetles that are already in the storage bin, it can help stop their populations from getting out of control and causing serious issues. “The key with aeration and quick cooling is that you don’t let insects multiply,” says Jian. “If you only have a few insects in your bin and they’re unable to produce more generations, then you generally won’t have a problem and be able to keep your grain quality safe.”

THURSDAY, NOVEMBER 20TH, 2025 10AM CT


SPEAKERS:
Courtney McClinton, P.Ag. | Agronomy Technical Services Manager (Western Canada)
Dan Tollefson Product Lead, FertilizerPlus, ICL
BY BRUCE BARKER
In the 10 years since Verticillium stripe was first identified in Manitoba, researchers have been working to gain a better understanding of the disease and its impact on canola production. A research study led by Sheau-Fang Hwang and Stephen Strelkov at the University of Alberta is shedding some light on the disease.
“The project was designed to mitigate the threat posed by Verticillium stripe to sustainable canola production through a variety of research activities,” says Hwang. The research started in 2019 and was wrapped up in March 2024.
Verticillium stripe is caused by the Verticillium longisporum pathogen. The most recent disease survey results in 2024 show that the disease continues to spread across the Prairies. The results of the 2025 field surveys will be available later in the fall/winter of 2025. The 2024 Manitoba general canola disease survey found that 60 per cent of fields surveyed had visual confirmation of Verticillium stripe with a mean incidence of 32.4 per cent in diseased fields. In Saskatchewan, DNA-based testing confirmed Verticillium stripe in 67 fields covering 32 per cent of fields surveyed.
“With almost one-third of Saskatchewan fields confirmed with Verticillium stripe infection in 2024, it’s no longer a surprise to find it anywhere in the province,” says Alireza Akhavan, Saskatchewan plant disease specialist based in Regina, Sask.
In Alberta, crop assurance lead Michael Harding says that Verticillium stripe continues to spread based on annual disease surveys. He reports that since 2020, the number of fields with suspicious symptoms and positive samples began increasing in 2023, reaching 25 positive fields in 2024. Additionally, canola growers and agronomists have reported Verticillium stripe in dozens of additional fields since 2022.
“Some of these fields have reported economically impactful disease severity. These positive fields from the surveys and anecdotal reports were not clustered or regionally isolated, indicating that there is potential risk virtually anywhere in Alberta,” says Harding.
Hwang and Strelkov’s research study had several components to help gain a better understanding of the

disease. There were four objectives, including the impact of the disease severity on yield loss and an evaluation of canola hybrids for resistance to Verticillium stripe. The researchers also investigated various inoculation methods and timing to develop tools to help study the disease. Finally, they looked at the interaction of Verticillium stripe and blackleg disease.
ABOVE Stephen Strelkov (L) and Sheau-Fang Hwang (R), professors at the University of Alberta, are working to gain a better understanding of Verticillium stripe.
Hwang says that since Verticillium stripe is an emerging disease in Canada, little research has been conducted on optimizing pathogen inoculation techniques. A canola hybrid and the old universally susceptible canola cultivar Westar were grown under greenhouse conditions. They were inoculated using a root-dip method at two inoculum concentrations and a grain inoculation method at four inoculum concentrations.
“It’s very important to develop effective inoculation methods for screening cultivars, testing fungicides or examining early pathogen–host interactions under
both controlled environments and field conditions,” says Hwang. “Root dipping usually generates very accurate results, because seedlings only contact water and spores, while grain inoculum mimics naturally infested soil conditions.”
Following root dip inoculation, Verticillium stripe symptoms showed up at early growth stages with seedling mortalities of 19.7 per cent for the canola hybrid and 33.3 per cent for Westar. Much greater mortality occurred at the high versus low inoculum concentrations.
Inoculation timing at one-, twoand three-week old seedlings were also compared with the root-dip method. Disease development was not significantly different between the inoculation timings.
Grain inoculation did not cause seedling mortality, but Verticillium stripe severity was significantly higher in the high inoculum treatment compared to the control. As inoculum concentration increased, plant dry weight and height decreased. The grain inoculum technique will most likely be suited to field studies or large-scale resistance screening.
As part of the research, the researchers used two disease severity scales. A 0-9 scale was developed to evaluate disease severity in canola seedlings. The 0-9 scale can be used to assess cotyledon yellowing/necrosis and stunting during the early stages of plant growth. The 0-5 scale evaluates the presence of microsclerotia and shredding of the stem at harvest.
“The two different scales are targeting two different sets of symptoms, one of which appears early in the growing season, while the other appears in the later stages of plant growth,” says Hwang. “The two different scales are based on prior work and are appropriate for Verticillium stripe research. Over time,

they may become more widely adopted.”
ABOVE Symptoms of Verticillium stripe, showing half-leaf yellowing.
Yield loss modelling was conducted in 2020 and 2021 at two infested fields near St. Albert, Alta. Single plant yield and plot yields were measured in relation to increasing disease severity. Single plant yield declined by up to 80 per cent under increasing disease severity and was well explained by a quadratic yield model. However, at the plot level, yield losses were not significant as disease severity increased.
“The quadratic equation is biologically relevant for individual plant yield but may overestimate field-scale yield loss because plant to plant compensation reduces aggregate losses. At the plot level, yield reductions were not significant because losses of diseased plants were offset by reduced competition—healthy neighbors had more space, nutrients and light to compensate for losses,” says Hwang. “At the field level, disease incidence, distribution and competition must also be considered.” Hwang hopes that further research will help to develop a robust disease severity–yield equation across cultivars and environments, similar to what has been developed for blackleg in canola.
Westar and five commercial canola
hybrids were inoculated at two V. longisporum concentrations and grown under greenhouse conditions. Seed germination of Westar was most severely affected with reductions of over 90 per cent at the highest inoculum concentration. In contrast, the most tolerant hybrid showed germination rates of almost 40 per cent at the high inoculum concentration.
Greenhouse and field experiments were conducted on two canola hybrids to see if there were interactions between Verticillium stripe and blackleg. Blackleg severity increased in the presence of Verticillium stripe, but Verticillium stripe did not increase in the presence of blackleg.
“Our study suggests Verticillium stripe may predispose plants to more severe blackleg, making blackleg management harder. Management strategies should account for both diseases,” says Hwang. “Since no Verticillium stripe resistance genes have been identified and no resistant cultivars are registered in Canada, the presence of Verticillium stripe may negatively affect blackleg resistance. Therefore, effective blackleg management can help reduce the damage caused by co-infection with both diseases, as higher blackleg severity is associated with greater yield losses.”
Overall, the research is helping to contribute to the body of work that is being conducted across the Prairies to better understand the disease, and to eventually help develop management strategies for the disease. This research was made possible by the Canola Agronomic Research Program funded by the Sask Oilseeds, Alberta Canola and the Manitoba Canola Growers Association. We also gratefully acknowledge the in-kind support provided by the University of Alberta.


by Bruce Barker, P.Ag |
With the evolution of pod shatter resistant hybrid canola, growers have shifted their management practices in an effort to maximize yield and reduce costs. A recent research project led by Brian Beres at Agriculture and Agri-Food Canada (AAFC) at Lethbridge, Alta. investigated how seeding rate, swathing canola and straight cutting pod shatter resistant canola hybrids impacted seed yield and quality.
The research was conducted between 2018 and 2022 (excluding 2020) at two sites near Lethbridge (irrigated and dryland), and one site at each of Lacombe, Alta., Indian Head, Sask. and Brandon, Man. Three seeding rates of six, 12 and 18 seeds/ft2 (60, 120 and 180 seeds/m2) that targeted plant stand densities of four, seven and 10 plants/ft2 (40, 70 and 100 plants/m2) were compared. InVigor L233P (early maturing) and InVigor L255PC (late maturing) pod shatter resistant varieties were compared.
For harvest method comparisons, researchers looked at windrowing at 60 per cent and 90 per cent seed colour change and straight cutting at 10 per cent and five per cent seed moisture. Reglone was applied to the straight cut treatments to achieve uniform dry down and to test pod shattering when harvest was delayed. The 90 per cent seed colour change and five per cent seed moisture straight cut treatments simulated a delayed harvest.
The field plots were sown into a cereal or pulse stubble with knife openers on nine- or 12-inch (23 or 30 cm) row spacings. Standard agronomic practices were applied to the plots.
The highest yields came from the later maturing L255PC variety compared to the earlier maturing L233P variety. Later maturing varieties typically yield higher as they have a longer growing season to capture more resources to increase yield.
Yield was also highest when the varieties were sown at 12 and 18 seeds/ft2, which resulted in plant stands of 5.7 and eight plants/ft2 on average. Canola seeded at six seeds/ft2 and windrowed yielded the lowest. For example, L255PC sown at six seeds/ft2 yielded 47 bu./ ac. (2.66 t/ha). However, when seeded at 12 or 18 seeds/ft2, it yielded 51 bu./ac. (2.86 t/ha).
Straight cutting canola also resulted in higher yield than windrowing canola. Data analysis found that yield was greatest for straight cut L255PC when

seeded at 12 or 18 seeds/ft2 compared to other treatment combinations. The average yield of L225PC when seeded at 12 or 18 seeds/ft2 and straight cut at 10 per cent seed colour change, or seeded at 18 seeds/ft2 and straight cut at five per cent seed colour was 4.3 bu./ac. (0.24 t/ha) higher than the other treatment combinations.
The analysis also found that most of the straight cut yields when seeded at 12 or 18 seeds/ft2 had the highest, most stable yields. For both hybrids, windrowed canola that was seeded at six seeds/ft2 had the lowest, most unstable yields. But the research also showed that the lowest seeding density works when environmental stress is low such as under irrigation. However, if there is stress such as drought, flea beetles and disease, plants cannot compensate enough through changes in yield components like additional branching and podding to maintain yield potential.
These seeding rate yield results are consistent with a meta-analysis conducted in 2020 by Hartman and Jeffrey. They found: “Hybrid canola achieved 95 per cent of its yield potential with 6.5 to 8.5 plants/ft2, 90 per cent with three to 4.5 plants/ft2 and 85 per cent with two to three plants/ ft2.”
Oil content was lower for L233P at 46.5 per cent compared to L255PC at 48.5 per cent. Straight cut L233P had slightly higher oil content than windrowed, while windrowed L255PC had slightly higher oil content than straight cut.
Canola at six seeds/ft2 lagged in crop development by up to five days but developed more branches and pods per plant. Increased intra-plant competition with higher seeding rates meant increased seed yield and seed weight on secondary branches, which were critical yield components.
Economic analysis showed there is a balance between seeding rate, yield and economic returns. Based on 2023 InVigor seed prices, the additional input cost for seeding at 18 seeds/ft2 would be $126/ac. ($311/ ha) higher than the six seeds/ft2 rate, and $63/ac. ($155/ha) higher than the 120 seeds/ft2 rate.
The estimated net return based on 2023 canola prices found that the 18 seeds/ft2 seeding rate was $79/ac. ($196/ha) less than the 12 seeds/ft2 rate and $50/ac. ($123/ha) less than the six seeds/ft2 rate. This would mean that 12 seeds/ft2 found the sweet spot and produced a net return $29 higher than the six seeds/ft2 seeding rate and $79/ac. more than the highest seeding rate.
Overall, for both early- and late-maturing hybrids, straight-cutting canola at 10 per cent seed moisture produced high, stable yields. While seeding at 18 seeds/ft2 produced the highest yield, it also had the lowest net returns due to high seed costs. Seeding at 12 seeds/ft2 provided a balance between yield, seed costs and net returns.
Bruce Barker divides his time between CanadianAgronomist.ca and as Western Field Editor for TopCropManager. CanadianAgronomist.ca translates research into agronomic knowledge that agronomists and farmers can use to grow better crops. Read the full research insight at CanadianAgronomist.ca.

It all starts with the soil. When it’s healthy, everything works better—stronger roots, improved structure, and more efficient use of nutrients. But after years of wear, many soils need support to perform at their best. Black Earth humic solutions help restore soil vitality from the ground up. With high-purity Humalite and consistent quality, our products enhance moisture retention, boost nutrient availability, and improve overall soil health—naturally. Easy to integrate and built for results, Black Earth gives your soil the foundation it needs for long-term productivity.
Scan the QR code or contact us to start elevating your soil today.

sales@blackearth.com www.blackearth.com

We’ve walked the fields. We know the conditions. With over four decades of putting research and development at the forefront, our seed doesn’t just perform in Western Canada, it’s designed for it.
